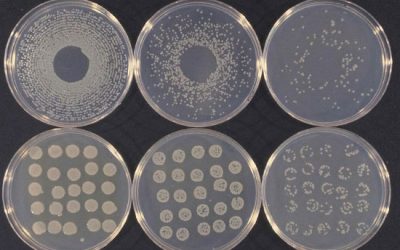
تست کلنی کانت با روش پخش کردن در محیط کشت - شرکت دانش بنیان بافت و ژن پاسارگاد
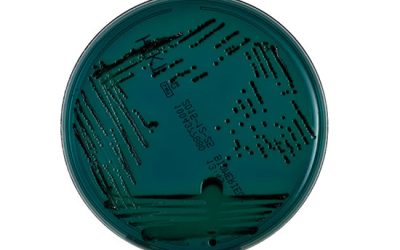
جداسازی و کشت افتراقی - شرکت دانش بنیان بافت و ژن پاسارگاد

خدمات میکروبیولوژی
انواع خدمات قابل ارائه در واحد مطالعات میکروبی مرکز علمی پژوهشی هیستوژنوتک:
- جداسازی و کشت افتراقی-انتخابی میکروارگانیسم ها
- انجام تست های فنوتیپی تعیین هویت میکروارگانیسم ها و شمارش کلونی
- انجام تست های تست های بیوشیمیایی، سرولوژیک و مولکولی در تشخیص میکروارگانیسم ها
- انجام تست های بررسی حساسیت آنتی بیوتیک M.I.C - M.B.C - Disk diffusion
- بررسی میزان توان تولید بیوفیلم و سنجش بیوفیلم
- بررسی بیان ژن در تولید بیوفیلم و ژن های مقاومت به آنتی بیوتیک
- بررسی آلودگی میکروبی در نمونه های مختلف (غذایی، آبی و…)
- سنتز نانو ذرات میکروبی و بررسی اثر نانو دارو ها بر میکروارگانیسم ها
- جدا سازی و تخلیص پروبیوتیک ها
- تخلیص پلاسمید، طراحی وکتور و انجام کلونینگ
- انجام رنگ آمیزی های عمومی و اختصاصی برای بررسی حضور میکروارگانیسم ها
- انجام تست کلنی کانت ( شمارش تعداد کلنی ) با روش پخش کردن در محیط کشت

میکروبیولوژی علم مطالعه ی ارگانیسم های میکروسکوپی مانند باکتری ها، ویروس ها، قارچ ها و تک یاخته ها در قلمروی پروکاریوت ها و یوکاریوت ها می باشد. امروزه علاوه بر اهمیت شگرف میکروبیولوژی در بیماری زایی و علم پزشکی، اهمیت این موجودات در صنعت، مواد غذایی و محیط زیست نیز بسیار مورد توجه می باشد.
مرکز علمی پژوهشی هیستوژنوتک با بهره مندی از برترین متخصصین، به روز ترین دستگاه ها و آخرین پژوهش های انجام شده در دنیا در صدد پیشرفت در این حوزه مهم بیولوژیک بوده و تلاش در تعریف طرح ها با اولویت بالای تولیدی و ارائه خدمات به روز به دانش پژوهان و محققان کشور را به عنوان هدف پیگیری می نماید.